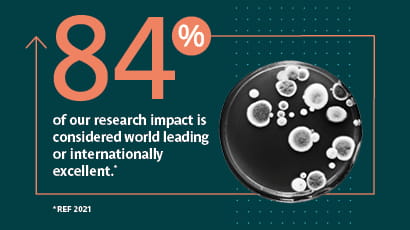

Ranking and reputation
Find out more about UWE Bristol's employability figures, league table positions and other important University rankings and metrics.
Why you should study at UWE Bristol

Gold rating for student experience in Teaching Excellence Framework (TEF)
Gold for outstanding student experience in the 2023 Teaching Excellence Framework (TEF)

90% in work or further study after 15 months
UWE Bristol has a strong reputation for graduate employability according to the Graduate Outcome Survey 21/22 (published 2024).
84% of our research impact is considered world leading or internationally excellent
According to the Research Excellence Framework (REF) 2021.

First university to achieve University Mental Health Charter Award with Merit.
UWE Bristol is the first university to achieve Award with Merit for continuous improvement in the area of mental health and wellbeing.

Top 15% apprenticeship provider in the UK for Qualification Achievement Rates, 2024
We’ve achieved 74% for the outcomes of our apprenticeships (Qualification Achievement Rate table 22/23) , placing us in the top 15% of all UK apprenticeship providers.

Sustainability Institution of the Year at the 2023 Green Gown Awards
UWE Bristol earns a national award which celebrates the inspirational sustainability work and projects of UK and Ireland Higher Education institutions.

Top 25% of universities worldwide for the international diversity of our students
We are ranked 185th globally for the diversity of our student population in the QS World University Rankings 2024.

Top 50% of universities globally for the diversity of our staff.
UWE Bristol is in the top 50% of universities worldwide for the diversity of our teaching staff. QS World University Rankings 2024.

Top 50% of universities globally for international research and collaboration
We rank in the top 50% of global universities for our international research and collaboration across the sector, in the UK and internationally. QS World University Rankings 2024.
You may also be interested in

Discover Bristol
Things to do in Bristol, location and city life.

Undergraduate study
Everything you need to know about undergraduate study at UWE Bristol including courses, accommodation, fees and funding, employability and life at UWE Bristol.

Work experience, jobs and placements
Find essential information to support your job and opportunity search in your industry sector.

Campus and facilities
We've invested £300 million into our modern facilities, creating the most effective and empowering setting for our students and people to discover their potential.